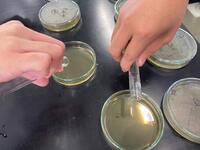

2023年11月の記事一覧
【本渡校舎】食品科学科1年生「パウンドケーキ製造」
本校の販売用パウンドケーキは膨張剤を使用せず、製造を行いますが今回はベーキングパウダーを使い、膨張剤の力を借りて、ケーキ製造を行いました。
今回は自分たちで計量、準備も行い、各班協力して行いました。




今回の製品には牛乳とラム酒を入れ、香り豊かなパウンドケーキが出来上がりました。
【本渡校舎】食品科学科3年生「乳酸菌の分離」
食品中に含まれる、乳酸菌の分離を行いました。
今回はヨーグルトとキムチの中から乳酸菌を取り出します。



一週間30℃で培養を行います。どうなっているでしょうか!?
【本渡校舎】食品科学科3年生「スイートカボチャ」製造
文化祭も終わり、久しぶりの持ち帰り実習!!
今回はカボチャを使ったお菓子作り。スイートカボチャを作りました。




カボチャを蒸して、バター、砂糖、生クリーム、卵黄を混ぜ成形しました。
生地が柔く、成形しにくかったですがおいしくできました!!
【本渡校舎】食品科学科「拓心祭に向けた製造実習記録」
先日の拓心祭にはたくさんの方々にご来場いただき、本学科の製品をご購入いただき誠にありがとうございました。
今回のブログでは、拓心祭に向けた実習の記録を紹介いたします。
【肉加工】




【製菓】


今後の実習予定は期末考査後にケーキー製造やソーセージ製造を予定しております。